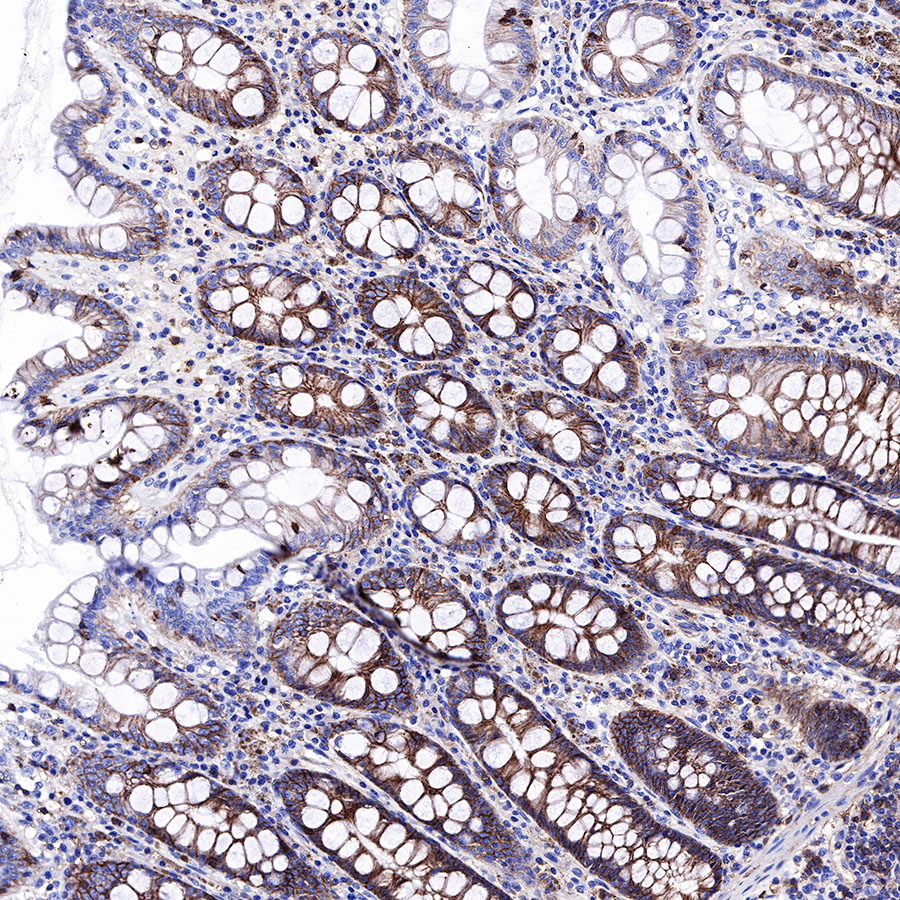
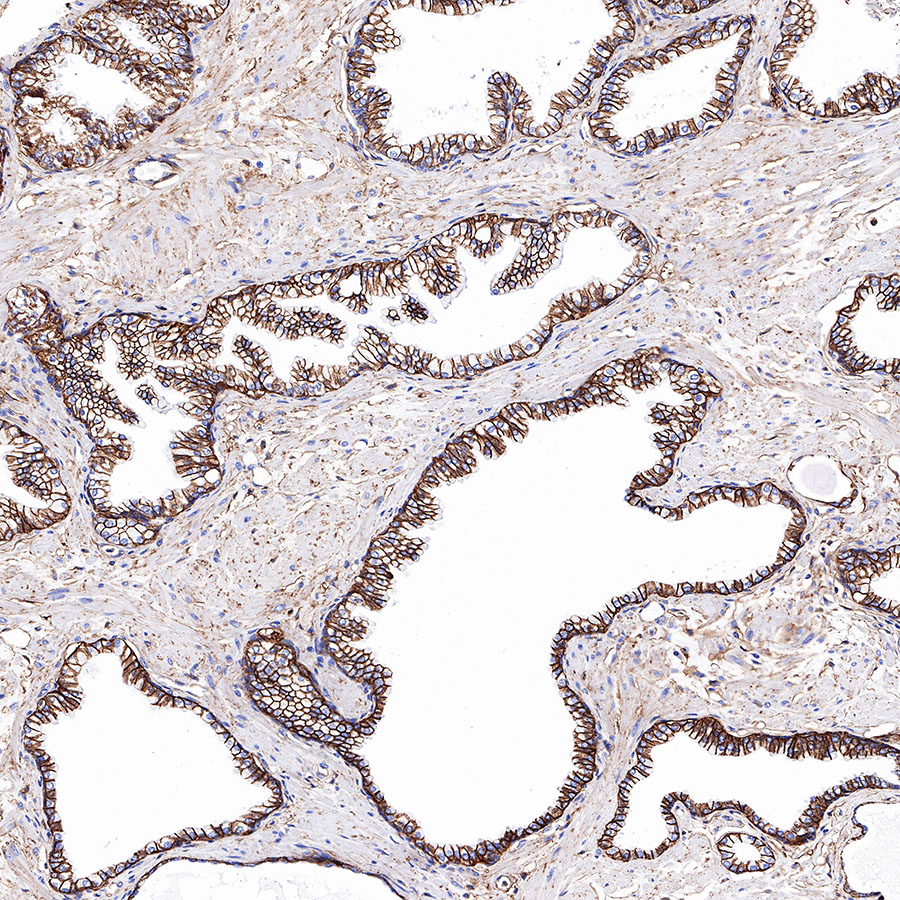
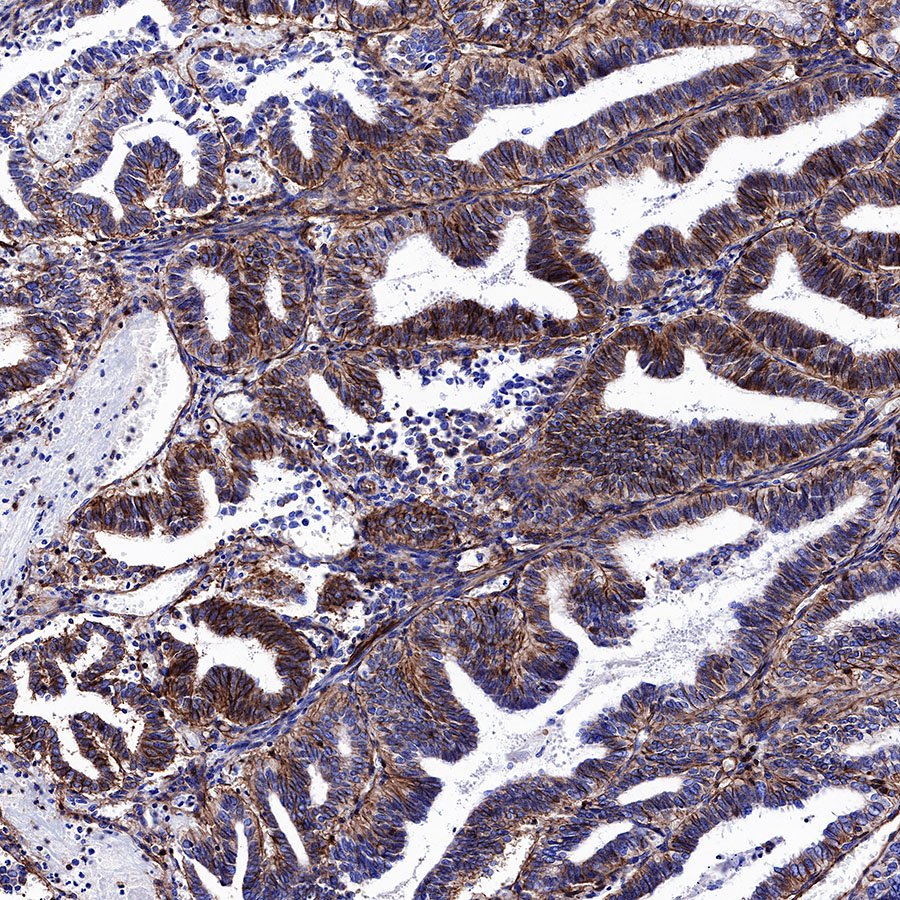
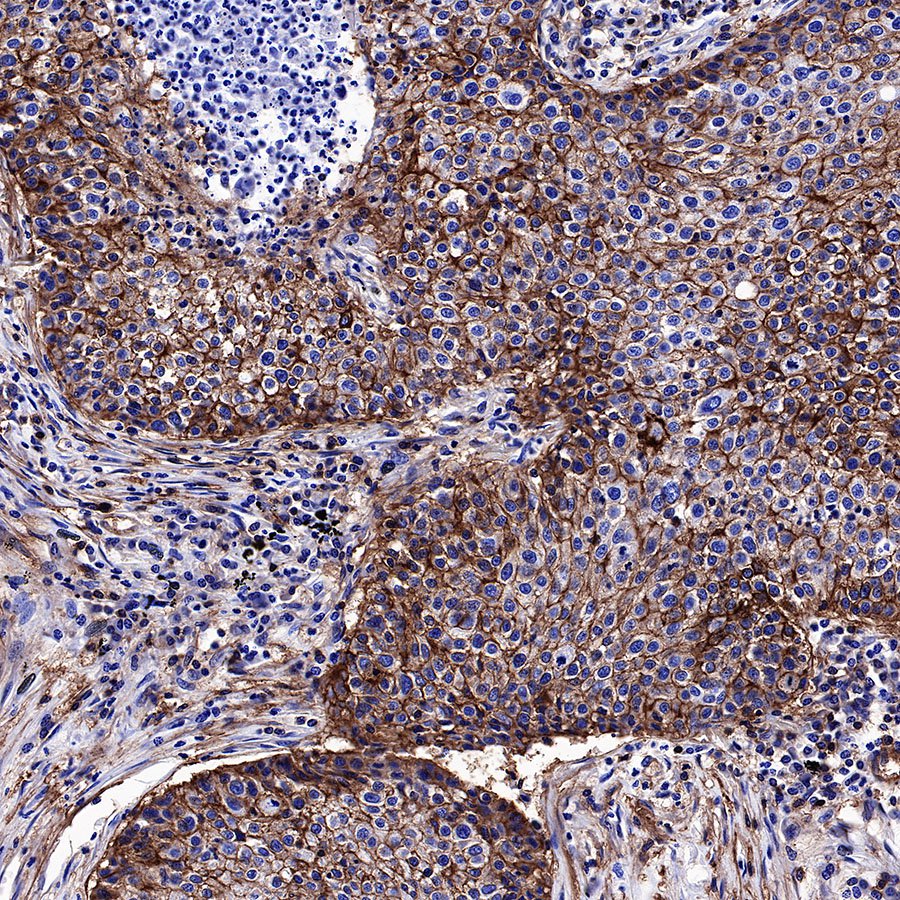
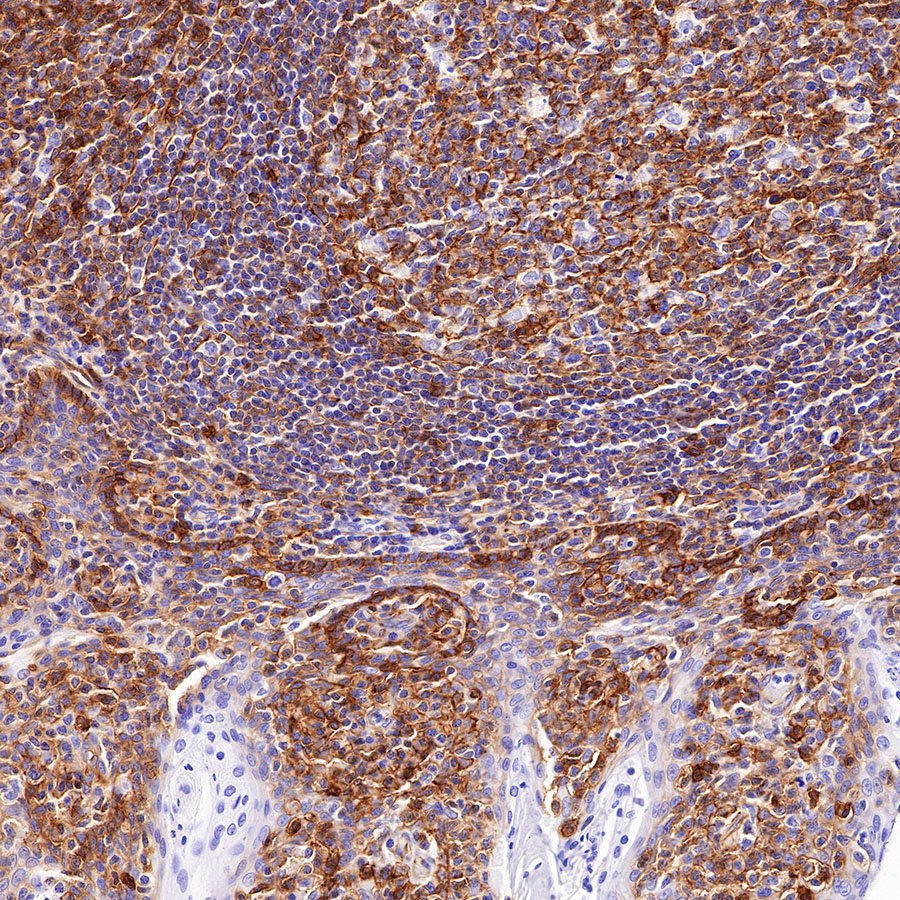

IHC shows positive staining in paraffin-embedded human pancreas. Anti-CD99 antibody was used at 1/1000 dilution, followed by a HRP Polymer for Mouse & Rabbit IgG (ready to use). Counterstained with hematoxylin. Heat mediated antigen retrieval with Tris/EDTA buffer pH9.0 was performed before commencing with IHC staining protocol.
Product Details
Product Details
Product Specification
| Host | Rabbit |
| Antigen | CD99 |
| Synonyms | 12E7, E2 antigen, Protein MIC2, T-cell surface glycoprotein E2 |
| Immunogen | N/A |
| Location | Membrane |
| Accession | P14209 |
| Clone Number | SDT-R122 |
| Antibody Type | Rabbit mAb |
| Application | WB, IHC-P, ICC, IF |
| Reactivity | Hu |
| Purification | Protein A |
| Concentration | 0.25 mg/ml |
| Physical Appearance | Liquid |
| Storage Buffer | PBS, 40% Glycerol, 0.05% BSA, 0.03% Proclin 300 |
| Stability & Storage | 12 months from date of receipt / reconstitution, -20 °C as supplied |
Background
CD99 is cell surface protein expressed on multiple diferent cell types, including lymphocytes, that is involved in a range of cellular processes including cellular adhesion and migration, apoptosis and cell survival, T-cell diferentiation, and cancer biology [PMID: 29305692, PMID: 29534016]. Moreover, CD99 is ofen expressed on myeloid and lymphoid leukemia cells and can both aid in leukemia diagnosis and correlate with prognosis [PMID: 27764235, PMID: 21487112, PMID: 30484860].
Picture
Picture
Western Blot

Immunohistochemistry

IHC shows positive staining in paraffin-embedded human colon. Anti-CD99 antibody was used at 1/1000 dilution, followed by a HRP Polymer for Mouse & Rabbit IgG (ready to use). Counterstained with hematoxylin. Heat mediated antigen retrieval with Tris/EDTA buffer pH9.0 was performed before commencing with IHC staining protocol.
IHC shows positive staining in paraffin-embedded human prostate. Anti-CD99 antibody was used at 1/1000 dilution, followed by a HRP Polymer for Mouse & Rabbit IgG (ready to use). Counterstained with hematoxylin. Heat mediated antigen retrieval with Tris/EDTA buffer pH9.0 was performed before commencing with IHC staining protocol.
IHC shows positive staining in paraffin-embedded human endometrial cancer. Anti-CD99 antibody was used at 1/1000 dilution, followed by a HRP Polymer for Mouse & Rabbit IgG (ready to use). Counterstained with hematoxylin. Heat mediated antigen retrieval with Tris/EDTA buffer pH9.0 was performed before commencing with IHC staining protocol.
IHC shows positive staining in paraffin-embedded human lung squamous cell carcinoma. Anti-CD99 antibody was used at 1/1000 dilution, followed by a HRP Polymer for Mouse & Rabbit IgG (ready to use). Counterstained with hematoxylin. Heat mediated antigen retrieval with Tris/EDTA buffer pH9.0 was performed before commencing with IHC staining protocol.

IHC shows positive staining in paraffin-embedded Ewing's sarcoma. Anti-CD99 antibody was used at 1/500 dilution, followed by a HRP Polymer for Mouse & Rabbit IgG (ready to use). Counterstained with hematoxylin. Heat mediated antigen retrieval with Tris/EDTA buffer pH9.0 was performed before commencing with IHC staining protocol.
IHC shows positive staining in paraffin-embedded human tonsil. Anti-CD99 antibody was used at 1/1000 dilution, followed by a HRP Polymer for Mouse & Rabbit IgG (ready to use). Counterstained with hematoxylin. Heat mediated antigen retrieval with Tris/EDTA buffer pH9.0 was performed before commencing with IHC staining protocol.
Immunocytochemistry

ICC shows positive staining in Jurkat cells. Anti-CD99 antibody was used at 1/250 dilution (Green) and incubated overnight at 4°C. Goat polyclonal Antibody to Rabbit IgG - H&L (Alexa Fluor® 488) was used as secondary antibody at 1/1000 dilution. The cells were fixed with 4%PFA and permeabilized with 0.1% PBS-Triton X-100. Nuclei were counterstained with DAPI (Blue). Counterstain with tubulin (red).
Immunofluorescence

IF shows positive staining in paraffin-embedded human Ewing's sarcoma. Anti-CD99 antibody was used at 1/100 dilution (Green) and incubated overnight at 4°C. Goat polyclonal Antibody to Rabbit IgG - H&L (Alexa Fluor® 488) was used as secondary antibody at 1/1000 dilution. Counterstained with DAPI (Blue). Heat mediated antigen retrieval with EDTA buffer pH9.0 was performed before commencing with IF staining protocol.

IF shows positive staining in paraffin-embedded human tonsil. Anti-CD99 antibody was used at 1/100 dilution (Green) and incubated overnight at 4°C. Goat polyclonal Antibody to Rabbit IgG - H&L (Alexa Fluor® 488) was used as secondary antibody at 1/1000 dilution. Counterstained with DAPI (Blue). Heat mediated antigen retrieval with EDTA buffer pH9.0 was performed before commencing with IF staining protocol.

IF shows positive staining in paraffin-embedded human pancreas. Anti-CD99 antibody was used at 1/100 dilution (Green) and incubated overnight at 4°C. Goat polyclonal Antibody to Rabbit IgG - H&L (Alexa Fluor® 488) was used as secondary antibody at 1/1000 dilution. Counterstained with DAPI (Blue). Heat mediated antigen retrieval with EDTA buffer pH9.0 was performed before commencing with IF staining protocol.
